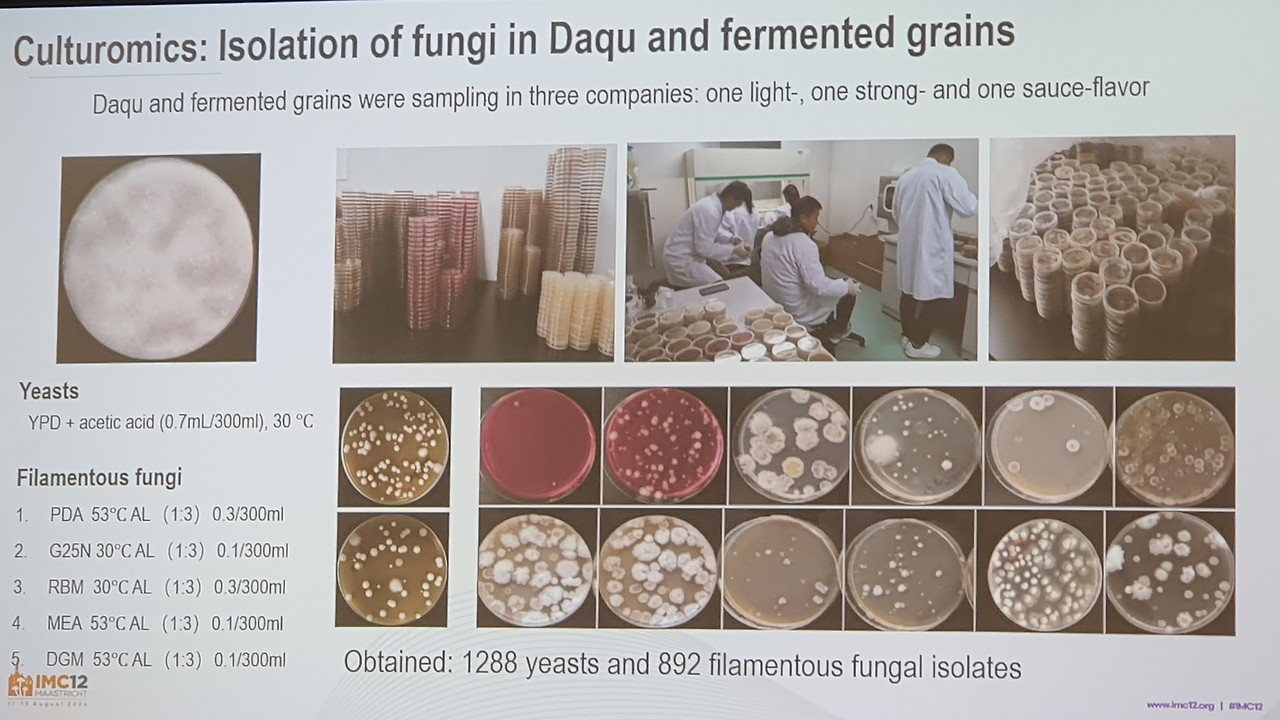
11-Baiju.jpg

중국 바이주 곰팡이
Microbiome of Baijiu fermentation
세계균학회 13차 대회에 참가하였다. 파리올림픽이 끝나는 8월 11일에 시작되어 5일간 열렸는데 가히 곰팡이 올림픽이라고 할 수 있을 만큼, 곰팡이의 다양한 분야에서, 세계 다양한 국가의 사람들이 참석하여 연구결과를 공유하였다.
평소에 관심이 있던 분야에 세계 최고의 학자들이 발표하는 자리인지라, 여러분야를 동분서주하며 다녔다. 하지만 많은 기대를 갖고 참석하면 영어도 잘 안 들리고, 이해도 어려워, 큰 기대만큼이나 자신에 대하여 실망이 크기도 하였다.
그래도 밥값은 해야되겠기에 국내 분들과 공유할 수 있는 것들을 찾아 열심히 들을려고 애썼다. 몇개 분야는 조금만 살을 보태면 그래도 국내인들과 최신 소식을 공유할 수 있겠는데, 귀국하면 일에 치여서 언제 글을 쓸 수 있을지 미지수다.
해서 아직 자료도 부족하지만, 우선 하나만이라도, 듣고 기록한 것을 위주로 해서, 뱅기 타기 전에 작업을 마치려고 한다.
이번 학회에는 78개의 쎄션이 있었는데 그 중 하나가 "곰팡이와 식품 - 가축화와 응용(Fungi and Foods- Domestiation and application)" 이었다. 가축화(domestication)라는 말이 생소할 수 있는데 늑대를 길들여서 개로 사용하는 것처럼, 야생 곰팡이를 길들여서 식품 제조에 사용하는 것을 말한다.
이 쎄션에서는 7개의 강의가 있었는데 서양이라 치즈곰팡이 연구 발표가 많았고, KFC의 햄버거의 패드로 쓰이는 곰팡이인 퀀(Quorn), 느타리버섯의 자실체가 아닌 균사를 이용한 식품, 중국의 백주 등의 흥미로운 곰팡이 연구가 소개되었다. 치즈곰팡이도 재미있고, 특히 퀀도 매우 흥미로운 소재인데 이들은 다음에 시간을 갖고 소개하기로 하고, 오늘은 우선 중국 백주 곰팡이에 대하여 듣고 본대로 그대로 소개하고자 한다.
서론 - 백주 곰팡이 연구 목적
 중국 바이주 발효의 미생물상 (발표 표지)
중국 바이주 발효의 미생물상 (발표 표지)발표제목은 백주발효의 마이크로바이옴이다. 이 연구는 중국의 대표 국가 연구소인 중국과학원(Chinese Academy of Science)과 네덜란드의 곰팡이 대표 연구소인 웨스트다이크(Westerdijk) 연구소가 주도 하였다. 그리고 귀주 마오타이 등의 중국 백주 제조사가 재료를 공급하였다.
스토리를 재구성할 여유는 없고 중국과학원 진균학국가중점연구실 소속의 Wang Suwei 박사가 발표한 순서대로 그대로 소개한다. Wang 박사랑 페이스북에 발표자료를 소개하는 것에 대하여 논의하였는데, 일부 슬라이드는 일반인에게 공유하는 것에 대하여 부담을 가져서, 여기에는 저자가 게재를 허락한 슬라이드만 게재하고, 공개를 원하지 않는 슬라이드는 해당 제목과 설명으로 대신한다.
술을 직접 제조하는 회사에서 연구한 것이 아니라, 중국과학원의 곰팡이 전문가들이 실험한 것이라서, 술에 대한 깊이 있는 내용은 기대하기 어렵고, 다만 중국 누룩인 다쿠(大曲)와 발효 곡물에서 곰팡이 상(flora)에 대하여는 신뢰할 만한 내용을 제공할 수 있다는 것을 미리 말씀드린다. 즉 실제 술 제조에 곰팡이를 응용하고자 하는 사람들은 실망할 수도 있음을 미리 이야기하고 시작한다.
 주류 발효
주류 발효백주로 들어가기 위하여 세계의 술들을 요약하고 있다. 서양의 술인 와인과 맥주는 곰팡이(사상균)를 쓰지 않고 효모만을 사용한다. 그리고 일본주는 여기에 곰팡이 황국균(Aspergillus oryzae)만 더한다. 하지만 백주는 다양한 미생물이 관여한다는 것을 강조하면서 발표는 시작된다.
 백주의 양조 과정
백주의 양조 과정백주의 양조 과정은 우리나라 소주의 제조 과정과 별반 다르지 않다. 다만 우리가 누룩을 만드는 대신에 중국은 다쿠(대곡)를 만들고, 쌀로 술을 빚는 반면에 주로 수수를 쓰고 일부 곡물을 추가한다. 다쿠를 만드는 온도에 따라 저온(45-50C), 중온(50-60C), 고온(60-65C) 제조로 나뉜다.
 백주 제조 주요 미생물
백주 제조 주요 미생물백주 제조에는 곰팡이(사상균), 효모, 세균, 혐기세균 등이 관여하는데 본 연구는 곰팡이와 효모를 대상으로 한다.
 아직까지 백주 제조 곰팡이 연구는 빈약한 상황이다.
아직까지 백주 제조 곰팡이 연구는 빈약한 상황이다.이전에도 다쿠 곰팡이에 대한 연구가 많이 있었지만 곰팡이 전문가에 의하여 수행 된 것이 아니라, 여전히 다쿠의 곰팡이에 대한 이해도가 낮고 부정확한 부분들이 있다.
 연구 목적
연구 목적그래서 본 실험의 목적은 (1) 백주 발효에 관여하는 곰팡이를 공부함으로써, (2) 백주 곰팡이의 기능과 유해성을 밝혀 백주의 품질과 안전성을 높이고, (3) 백주 제조의 종균으로 사용할 곰팡이를 확보하는데 있다.
 백주 향의 화학적 기반
백주 향의 화학적 기반백주는 다양하고 강한 향을 가지는 것으로 유명하다.
백주 곰팡이의 메타바코딩(비배양) 연구
 1장 다쿠(백주용 누룩)의 메타바코딩 연구. 메타바코딩은 미생물을 분리하지 않고 미생물을 포함한 샘플의 유전자를 일시에 분석하여 어떤 미생물들이 존재하는 지를 확인하는 실험 방법
1장 다쿠(백주용 누룩)의 메타바코딩 연구. 메타바코딩은 미생물을 분리하지 않고 미생물을 포함한 샘플의 유전자를 일시에 분석하여 어떤 미생물들이 존재하는 지를 확인하는 실험 방법첫번째 실험은 다쿠에서 곰팡이를 분리하지 않고 다쿠째로 유전자를 분석하여 어떤 곰팡이가 있는지를 확인하는 메타바코딩 실험을 하였다.
다쿠를 만드는 방법과 지역에 따라 바이주의 향이 서로 다르다. 백주는 다쿠의 발효 방법에 따라, 황하강 이북에서 저온발효(LTD, Low Temperature Daqu)로 만드는 약한 향(light aroma) 백주, 그리고 양쯔강 이북에서 중온발효(MTD, Midium Temperature Daqu)로 만드는 강한 향(strong aroma) 백주, 그리고 쓰촨과 귀주 지역에서 고온발효(HTD, High Temperature Daqu)로 만들어 지는 쏘스향(sauce aroma) 백주 등이 있다. 물론 이외에도 다양한 향을 내는 다양한 백주들이 있다(참고: 백주의 아로마 형태, https://www.lovebaijiu.com/baijiu-aroma-types/)
중국의 10개 성에서 다쿠 형태와 지역을 대표하는 296개의 다쿠를 수집하였다. 여기서 부터는 저온발효 백주(Low Temperature Daqu), 중온발효백주(Medium Temperature Daqu), 고온발효 백주(High Temperature Daqu)를 줄여서 각각 LFD, MFD, HFD로 부른다.
이들은 488개의 다양한 곰팡이 유전자형(ASV)으로 구성되었다.
 다양한 지역의 3개 다쿠 발효타입에 따른 곰팡이 구성
다양한 지역의 3개 다쿠 발효타입에 따른 곰팡이 구성296 샘플에 발생한 곰팡이는 다쿠의 발효 타입에 따라서 크게 달랐다. 먼저 LTD(저온 발효 백주)에서는 녹색, 적색, 청색 곰팡이가 비교적 고르게 분포하였으나 MTD(중온발효 백주)에서는 청색이, HTD(고온발효 청주)에서는 적색곰팡이가 우점하였다. 그리고 다쿠의 같은 발효타입일지라도 지역마다 달랐다. 특히 LTD의 경우에는 지역에 따라 곰팡이 분포가 확연히 구분되었다.
<슬라이드 제목: 다쿠의 3가지 발효 타입에 따른 곰팡이 구성(저자가 비공개를 요구함에 따라 설명만 제공>
296개의 다쿠에서 메티바코딩으로 확인된 곰팡이는 털곰팡이 목이 39.5%, Saccharomycopsis를 포함한 Ascoideales목 효모가 21%, Pichia를 포함하는 Pichiales목이 15.4%, 그리고 아스페곰팡이, 푸른곰팡이를 포함하는 Eurotiales 목이 20%였다. 다쿠 형태에 따르면 LTD는 Saccharomycopsis, Pichia, Lichtheimia 순으로 우점하였고, MTD는 Lichtheimia, Pichia, Aspergillus 순으로 많았고, HTD는 Thermomyces, Saccharomycopsis가 우점하였는데, 특히 마오타이로 유명한 귀주 지역의 다쿠로 부터는 다양한 곰팡이들을 골고류 확인할 수 있었다.
<rDNA ITS 기반의 곰팡이 동정>
488개의 곰팡이 유전자형은 86종(species)로 동정되었다. 이들은 크게는 6개 목(order)에 속하는 효모, 털곰팡이, 뿌리곰팡이, 솜사탕곰팡이로 대표되는 털곰팡이목(Mucorales), 그리고 푸른곰팡이(Penicillium)와 아스페곰팡이(Aspergillus)도 대표되는 Eurotiales 목으로 구성되었다.
백주 곰팡이의 배양 연구
 다쿠와 발효 곡물로부터 곰팡이의 분리
다쿠와 발효 곡물로부터 곰팡이의 분리이제까지는 곰팡이를 다쿠와 발효곡물로부터 분리 배양하지 않고 전체 유전자를 조사하여 어떤 곰팡이가 있는지를 확인하였다. 지금부터는 다쿠와 발효곡물로부터 실제 곰팡이를 분리 배양하여 실험한다.
LTD, MTD, HTD를 대표하는 각 하나의 회사(HTD를 대표하는 회사는 마오타이 생산 회사인 것으로 추정된다.), 즉 3개의 회사로부터 5개 배지를 이용하여 직접 곰팡이를 분리하였다. 효모 1288 균주, 곰팡이 892 균주를 분리하였다.
<다쿠와 발효곡물에서 효모의 동정 >
효모는 57종이 동정되었는데 Pichia, Saccharomycopsis, Toluraspora, Wicherhamoyces가 3개 발효타입 모두에서 분리되었다.
< 백주발효에서의 곰팡이(사상균) 동정>
35종의 Eurotiales 목, 10종의 털곰팡이목이 동정되었다. Aspergillus와 Thermoascus, 그리고 Rhizomucor, Rhizopus 곰팡이가 세 개 모두의 다쿠 발효타입으로부터 분리되었다.
<질문: 다쿠에 누룩곰팡이는 황국균(Aspergillus oryzae)인가? 노란아스페곰팡이(Aspergillus flavus)인가? >
우리나라 누룩처럼 다쿠에서도 황국균/노란아스페곰팡이가 자주 분리되는데, 과연 이들은 아플라톡신을 생성하지 않는 안전한 황국균인가, 아니면 아플라톡신을 생산하는 노란아스페곰팡이인가? 이부분은 다쿠의 안전성과 연관이 되기 때문에 중국에서도 매우 관심이 높은 분야이다.
<백주 발효환경에서 가축화가 진행되었다.>
황국균, 노란아스페곰팡이 종복합체를 조사한 결과 7% 미만만이 아플라톡신을 생성할 수 있는 노란아스페 곰팡이었다. 노란아스페곰팡이도 아플라톡신을 매우 미약하게 생성하였다. 야생에는 노란아스페곰팡이가 많은데 다쿠에는 황국균이 주를 이룬다는 것은 노란아스페곰팡이(늑대)가 온순한 황국균(개)으로 가축화가 되었다고 할 수 있다.
 다쿠와 발효곡물 배양실험 결과 요약
다쿠와 발효곡물 배양실험 결과 요약LTD, MTD, HTD를 대표하는 각 1개회사, 총 3개회사의 다쿠와 발효곡물로부터 6개 배지를 사용하여 곰팡이와 효모를 분리하였다.
1) 효모 1288균주, 곰팡이 892균주를 분리하였다.
2) 다쿠와 발효곡물로부터 Eurotiales 35종, 털곰팡이문 10종, 효모 57종 총 102종의 곰팡이를 분리하였다.
(비배양 메타바코팅으로 확인한 종의 76%까지 실제 배양하였다고 한다.)
3) 백주의 황국균은 아플라톡신 발생이 매우 낮으므로 가축화가 진행된 증거를 보여 주었다.
향후 연구 계획
 향후의 다쿠의 생산 방법에 변화가 있을 것이다.
향후의 다쿠의 생산 방법에 변화가 있을 것이다. 안전성, 고품질, 재현성을 높이기 위하여 각 회사는 고유의 곰팡이 조합의 접종원을 개발할 것이다. 버섯을 인공배양하듯이 다쿠도 각 회사의 특징적인 종균을 접종하여 생산할 것이다.
 백주 발효의 곰팡이 책 발간 예정
백주 발효의 곰팡이 책 발간 예정백주 발효에 관여하는 곰팡이를 모아서 책을 발간할 예정이다. 각 종에 대하여 형태, 생리, 생태, 유전적인 특징을 정리할 것이고 이들의 다쿠에서 기능을 기록할 예정이다.
결과 요약
결과 요약(1) 다쿠의 곰팡이는 LTD, MTD, HTD의 형태에 따라 지역에 따라 매우 다양하였다.
(2) 백주로부터 곰팡이가 100종 이상이 확인되어 백주에는 매우 다양한 곰팡이가 존재함을 확인하였다.
(3) 백주 발효에서 Eurotials, 털곰팡이목, 효모가 우점하였다.
(4) 본실험에서 분리된 균주들은 추가 연구를 통하여 가축화(산업적 활용) 되어 사용될 것이다.

시사점
중국의 백주 제조 누룩에 대한 연구는 그간 많이 진행되었다. 사실 이 연구도 내용에 특별히 선진적인 것이 있거나, 특이한 실험 기법이 제시된 것은 아니다.
하지만 중국의 대표적인 연구기관인 중국과학원(Chinese Acadey of Science) 미생물연구소에서 백주 누룩(다쿠)에 대하여 체계적인 연구를 하는 것은 그 의의가 크다. 왜냐면 이 연구소는 세계적인 미생물을 은행(CGMCC)을 가지고 있고, 세계미생물정보센터(WDCM)를 연구소 내에 보유할 만큼 데이터를 잘 관리하고 있다.
즉, 이 연구를 통하여 얻어진 메타게놈 정보, 유전체 정보 등을 연구소 내의 데이터뱅크를 통하여 관리하고 이를 국내외에 서비스 할 것이다. 마찬가지로 분리된 곰팡이 균주들 역시 관리 되면서 후속 연구에 사용될 것이다.
다시 말해서, 본 연구에서 저자들은 다쿠를 황하강 이북의 저온발효다쿠, 양쯔강 이북의 중온발효다쿠, 그리고 귀주 지역의 고온발효다쿠로 나누고 해당 지역에서 296개의 다쿠를 수집하여 분석하고, 또한 곰팡이 균주를 보관하였다. 그러면 이 연구소는 미생물 자원, 정보 관리 플랫폼이 좋기 때문에, 이를 바탕으로 중국의 백주 연구에 두고두고 활용될 것이다.
이것이 결국 중국의 힘이다.
......,
2024. 8. 17. 스키폴 공항에서 곰박